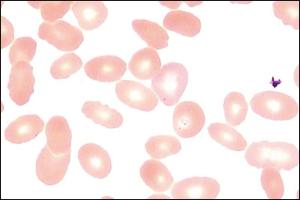
附红细胞体病

附红细胞体病是附红细胞体寄生于多种动物和人的红细胞表面、血浆及骨髓等部位所引起的一种人畜共患传染病。附红细胞体是介于原虫和立克次体之间的单核细胞性原核生物,传染源是感染了附红体的人、牛、羊、猪。畜牧地区人群中附红细胞体病感染率相当高。附红细胞体病主要临床表现为发热、乏力、出汗、嗜睡、关节痛、贫血、浅表淋巴结肿大等。附红细胞体病主要的治疗方法是药物治疗和对症支持治疗,可治愈。如果体内有60%以上的红细胞受到附红细胞体的感染,就会出现较严重的临床症状,甚至会导致死亡。如果症状较轻,及时治疗后,附红细胞体病的预后较好。
本页面主要目录有关于附红细胞体病的:就诊科室、病因、症状、检查、诊断、鉴别诊断、治疗、危害、预后、预防、参考文献等介绍